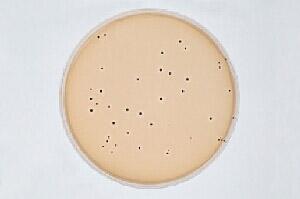
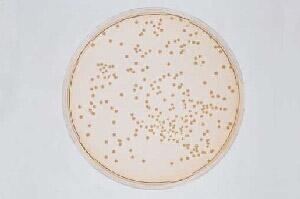
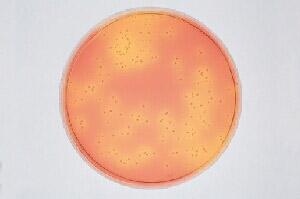
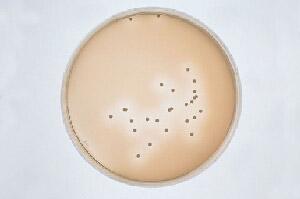
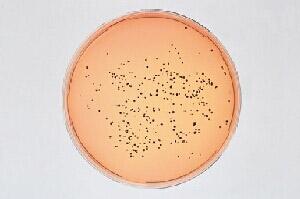

海博微信公众号
海博微信公众号
 海博天猫旗舰店
海博天猫旗舰店


 海博微信公众号
海博微信公众号
 海博天猫旗舰店
海博天猫旗舰店




典型特征:
A、在B-P平板上:呈圆形,表面光滑、凸起、湿润,直径2~3mm。灰黑色至黑色,有光泽,常有浅色(非白色)的边缘,周围绕以不透明圈(沉淀),其外常有一清晰带(卵磷脂环)。当用接种针触及菌落时具有黄油样粘稠感。有时可见到不分解脂肪的菌株,除没有不透明圈和清晰带外,其他外观基本相同。从长期贮存的冷冻或脱水食品中分离的菌落,其黑色常较典型菌落浅些,且外观可能较粗糙,质地较干燥。
B、在血琼脂上:白色菌落,在其周围有溶血环。
C、金黄色葡萄球菌在CHAPMAN培养基上 :
D、金黄色葡萄球菌在甘露醇高盐琼脂培养基上:黄色菌落,在其周围有黄色的环
E、金黄色葡萄球菌在DNA酶琼脂培养基上:黑色菌落,在其周围有白色的环
F、金黄色葡萄球菌在Vogel-Johnson培养基上:黑色菌落
金黄色葡萄球菌在葡萄球菌增菌培养基上

金黄色葡萄球菌在B-P培养基上
金黄色葡萄球菌在血琼脂上出现溶血环

金黄色葡萄球菌在CHAPMAN培养基上
金黄色葡萄球菌在甘露醇高盐琼脂培养基上
金黄色葡萄球菌在DNA酶琼脂培养基上
金黄色葡萄球菌在Vogel-Johnson培养基上
下一篇:沙门氏菌的典型特征



